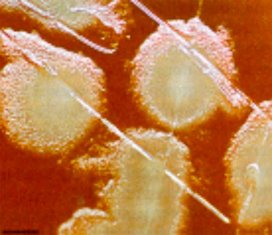

Op een verpleegafdeling in het Deventer Ziekenhuis is de MRSA bacterie ontdekt.
Op de desbetreffende verpleegafdeling liggen patiënten van interne geneeskunde en oncologie. Nadat de bacterie bij een van hen werd gesignaleerd, zijn direct 25 medewerkers van de afdeling getest. Uiteindelijk bleek dat ook een van de medewerkers met de bacterie besmet is, meldt het ziekenhuis.
Geen opnamestop
De zorg op de afdeling gaat gewoon door, er is geen opnamestop. Bezoekers wordt gevraagd alleen de eigen patiënt te bezoeken en bij het verlaten van de kamer de handen te desinfecteren met handalcohol.
Deventer Ziekenhuis
Door: redactie Nursing
Lees ook:
– 9 praktische vragen over MRSA
– Weblog: De nadelen van geïsoleerd verplegen
– Richtlijn MRSA herzien
– Dossier MRSA
Geef je reactie
Om te kunnen reageren moet je inlogd zijn. Inloggen Ik heb nog geen account